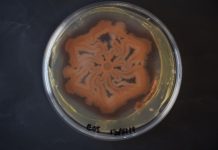
Study: New technique for engineering living materials and patterns Study: New technique for engineering living materials and patterns

Latest Articles
More
Scientists join Riverdance to investigate extreme demands of elite dance
SCIENTISTS have launched a pioneering study with the cast of Riverdance to examine the demands of elite-level live dancing.
The investigation, led by the University...
Research reveals “extensive network” of industry ties with healthcare
Results document pathways for potential influence across the system; better oversight needed to preserve public trust in healthcare, say researchers
The medical product industry maintains...
Research finds excess use of non-emergency restraint among older psychiatric patients
Restrictive interventions like acute control medications and restraints are more likely to be used in non-emergency situations among older psychiatric inpatients than younger ones,...
Composite glass breakthrough by Queensland scientists could help make phone screens ‘unbreakable’
Cracked phone screens could become a thing of the past thanks to breakthrough research by a global team of scientists.
Diamond’s electron Physical Science...
80 percent of world economy now aiming for net zero – but not all...
More than 80% of global GDP – and 77% of global greenhouse gases - are now covered by a national net zero target, up...